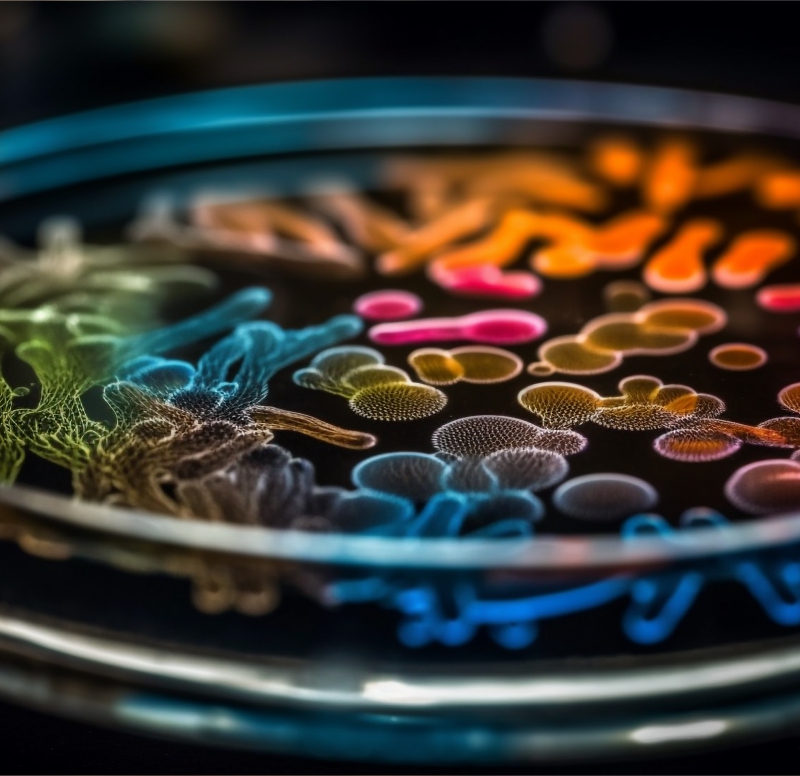

B.Sc. (Hons) in microbiology
About
B.Sc. (Hons) microbiology
B.Sc. (Hons) in microbiology is an undergraduate degree program dedicated to the scientific study of plants, algae, fungi, and their interactions with the environment. The course covers subjects such as plant anatomy, physiology, taxonomy, genetics, ecology, and economic microbiology. Students gain both theoretical knowledge and practical skills through laboratory work, field studies, and research projects. Graduates can pursue careers in research, environmental management, agriculture, forestry, biotechnology, and education, or opt for higher studies in specialized fields of plant sciences.
Why Study in B.Sc. (Hons) microbiology
Research & Analytical Skills
Conduct experiments, field studies, and data analysis to investigate botanical problems and environmental issues.

Career Opportunities
Prepare for careers in research, agriculture, forestry, biotechnology, education, and environmental management, or pursue higher studies in plant sciences.

Environmental Awareness
Promote sustainable practices and biodiversity conservation through botanical knowledge.

Duration: 4 years (Semester System)
Affiliation
A recognized constituent institution under Gokul Global University.

Eligibility Criteria
Candidate shall have passed 12th Examination in Science stream with Physics, microbiology & Biology subjects from a recognized board.

Mode of Admission
As per the guidelines and procedure prescribed by Council.

Curriculum
| # | Course Code | Course Name | Type | Credits | Theory | Tutorial | Practical | Detail Syllabus |
|---|---|---|---|---|---|---|---|---|
| 1 | 2301DU002 | Environmental Studies | BS | 2 | 2 | 0 | 0 |

|
| 2 | 2301HS101 | microbiology - I | BS | 6 | 4 | 2 | 0 |

|
| 3 | 2301HS103 | Physics | BS | 5 | 4 | 0 | 2 |

|
| 4 | 2301CS101 | Computer Programming using C | ES | 6 | 4 | 0 | 4 |

|
| 5 | 2301CS102 | Digital Fundamentals | ES | 5 | 3 | 2 | 0 |

|
| 6 | 2301ME103 | Engineering Graphics | ES | 4 | 2 | 0 | 4 |

|
| 7 | 2301DU003 | Indian Constitution | HS | 2 | 2 | 0 | 0 |

|
| 8 | 2301DU001 | Induction Program | MC | 0 | 0 | 0 | 0 |

|
| Total | 30 | 35 Hrs / Week | ||||||
| # | Course Code | Course Name | Type | Credits | Theory | Tutorial | Practical | Detail Syllabus |
|---|---|---|---|---|---|---|---|---|
| 1 | 2301DU002 | Environmental Studies | BS | 2 | 2 | 0 | 0 |

|
| 2 | 2301HS101 | microbiology - I | BS | 6 | 4 | 2 | 0 |

|
| 3 | 2301HS103 | Physics | BS | 5 | 4 | 0 | 2 |

|
| 4 | 2301CS101 | Computer Programming using C | ES | 6 | 4 | 0 | 4 |

|
| 5 | 2301CS102 | Digital Fundamentals | ES | 5 | 3 | 2 | 0 |

|
| 6 | 2301ME103 | Engineering Graphics | ES | 4 | 2 | 0 | 4 |

|
| 7 | 2301DU003 | Indian Constitution | HS | 2 | 2 | 0 | 0 |

|
| 8 | 2301DU001 | Induction Program | MC | 0 | 0 | 0 | 0 |

|
| Total | 30 | 35 Hrs / Week | ||||||
| # | Course Code | Course Name | Type | Credits | Theory | Tutorial | Practical | Detail Syllabus |
|---|---|---|---|---|---|---|---|---|
| 1 | 2301DU002 | Environmental Studies | BS | 2 | 2 | 0 | 0 |

|
| 2 | 2301HS101 | microbiology - I | BS | 6 | 4 | 2 | 0 |

|
| 3 | 2301HS103 | Physics | BS | 5 | 4 | 0 | 2 |

|
| 4 | 2301CS101 | Computer Programming using C | ES | 6 | 4 | 0 | 4 |

|
| 5 | 2301CS102 | Digital Fundamentals | ES | 5 | 3 | 2 | 0 |

|
| 6 | 2301ME103 | Engineering Graphics | ES | 4 | 2 | 0 | 4 |

|
| 7 | 2301DU003 | Indian Constitution | HS | 2 | 2 | 0 | 0 |

|
| 8 | 2301DU001 | Induction Program | MC | 0 | 0 | 0 | 0 |

|
| Total | 30 | 35 Hrs / Week | ||||||
| # | Course Code | Course Name | Type | Credits | Theory | Tutorial | Practical | Detail Syllabus |
|---|---|---|---|---|---|---|---|---|
| 1 | 2301DU002 | Environmental Studies | BS | 2 | 2 | 0 | 0 |

|
| 2 | 2301HS101 | microbiology - I | BS | 6 | 4 | 2 | 0 |

|
| 3 | 2301HS103 | Physics | BS | 5 | 4 | 0 | 2 |

|
| 4 | 2301CS101 | Computer Programming using C | ES | 6 | 4 | 0 | 4 |

|
| 5 | 2301CS102 | Digital Fundamentals | ES | 5 | 3 | 2 | 0 |

|
| 6 | 2301ME103 | Engineering Graphics | ES | 4 | 2 | 0 | 4 |

|
| 7 | 2301DU003 | Indian Constitution | HS | 2 | 2 | 0 | 0 |

|
| 8 | 2301DU001 | Induction Program | MC | 0 | 0 | 0 | 0 |

|
| Total | 30 | 35 Hrs / Week | ||||||
| # | Course Code | Course Name | Type | Credits | Theory | Tutorial | Practical | Detail Syllabus |
|---|---|---|---|---|---|---|---|---|
| 1 | 2301DU002 | Environmental Studies | BS | 2 | 2 | 0 | 0 |

|
| 2 | 2301HS101 | microbiology - I | BS | 6 | 4 | 2 | 0 |

|
| 3 | 2301HS103 | Physics | BS | 5 | 4 | 0 | 2 |

|
| 4 | 2301CS101 | Computer Programming using C | ES | 6 | 4 | 0 | 4 |

|
| 5 | 2301CS102 | Digital Fundamentals | ES | 5 | 3 | 2 | 0 |

|
| 6 | 2301ME103 | Engineering Graphics | ES | 4 | 2 | 0 | 4 |

|
| 7 | 2301DU003 | Indian Constitution | HS | 2 | 2 | 0 | 0 |

|
| 8 | 2301DU001 | Induction Program | MC | 0 | 0 | 0 | 0 |

|
| Total | 30 | 35 Hrs / Week | ||||||
| # | Course Code | Course Name | Type | Credits | Theory | Tutorial | Practical | Detail Syllabus |
|---|---|---|---|---|---|---|---|---|
| 1 | 2301DU002 | Environmental Studies | BS | 2 | 2 | 0 | 0 |

|
| 2 | 2301HS101 | microbiology - I | BS | 6 | 4 | 2 | 0 |

|
| 3 | 2301HS103 | Physics | BS | 5 | 4 | 0 | 2 |

|
| 4 | 2301CS101 | Computer Programming using C | ES | 6 | 4 | 0 | 4 |

|
| 5 | 2301CS102 | Digital Fundamentals | ES | 5 | 3 | 2 | 0 |

|
| 6 | 2301ME103 | Engineering Graphics | ES | 4 | 2 | 0 | 4 |

|
| 7 | 2301DU003 | Indian Constitution | HS | 2 | 2 | 0 | 0 |

|
| 8 | 2301DU001 | Induction Program | MC | 0 | 0 | 0 | 0 |

|
| Total | 30 | 35 Hrs / Week | ||||||
B.Sc.
₹ 25,000 Annually*
* Tuition Fees may vary depending on the Country/ State in which the candidate has passed their qualifying examination.
Laboratories



Activities
Event
26/11/2024
Event
18/10/2024
Event
21/10/2024
Event
15/10/2024
Achievement
17/10/2024
Achievement
16/10/2024
VISIT
15/10/2024
Event
10/10/2024
Seminar
05/10/2024
Seminar
4/10/2024
Seminar
03/10/2024
Freshers
03/10/2024
Seminar
03/10/2024
Village visit
02/10/2024
Seminar
28/09/2024
seminar
23/09/2024
Event Of Welcomimg
21/09/2024
Seminar
18/09/2024
seminar
10/09/2024
seminar
10/09/2024
seminar
10/09/2024
celebration
07/09/204
Celebration
05/09/2024
Event
02/09/2024
Event
26/08/2024
Expert lectures
24/08/2024
Start-up Skill India
23/08/2024
Birthday
17/08/2024
"VIKSIT BHARAT 2047"
15/08/2024
Campaign
14/08/2024
Event
14/08/2024
Event
10/08/2024
Event
07/08/2024
Event
05/08/2024
Board Meeting
02/08/2024
Event
31/07/2024
Event
27/07/2024
Event
27/07/2024
Event
05/07/2024
Achievement
05/02/2025
Seminar
08/02/2025
Achievement
10/03/2025
Event
17/03/2025
Event
08/03/2025
Seminar
08/03/2025
Visit
07/03/2025
Event
23/02/2025
Event
18/05/2025
Admissions Open for
A.Y. 2025-26
A university shapes futures. At Gokul Global University, we empower students through skill-based learning for lasting career success
















































